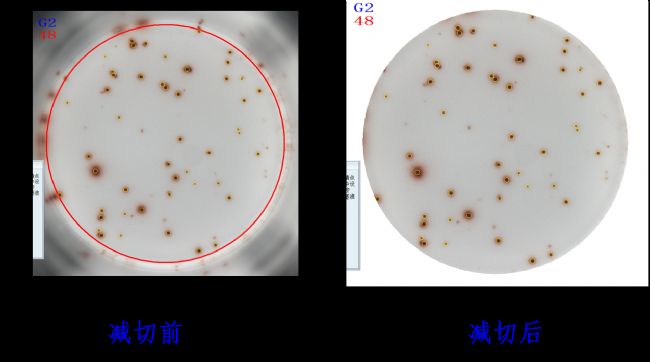

北京森西賽智科技有限公司(Beijing SinSage Technology Co.,Ltd)今天宣布,自主創(chuàng)新的新一代AT-Spot系列“酶聯(lián)免疫斑點圖像分析儀”正式發(fā)布。
20多年來,森西賽智科技一直在為不斷壯大的中國科研團隊提供的儀器、設(shè)備和技術(shù)支持。AT-Spot系列“酶聯(lián)免疫斑點圖像分析儀”秉持了森西賽智科技產(chǎn)品一貫的優(yōu)秀品質(zhì),是生命科學(xué)儀器領(lǐng)域民族創(chuàng)新的典范。
AT-Spot系列“酶聯(lián)免疫斑點圖像分析儀”擁有穩(wěn)定的客戶基礎(chǔ),新一代產(chǎn)品將繼承其優(yōu)秀的軟硬件設(shè)計,并進一步提高其成像和分析能力。憑借其功能強大的成像系統(tǒng)、SOP標準化操作軟件設(shè)計和具有多種獨特分析方法的圖像分析軟件,可以幫助中國越來越多的相關(guān)領(lǐng)域的生命科學(xué)專業(yè)人士實現(xiàn)他們的研究目標。森西賽智科技將繼續(xù)秉承“卓越品質(zhì),專業(yè)服務(wù)”理念,提供最先進的酶聯(lián)免疫斑點成像分析系統(tǒng)及其應(yīng)用支持。
關(guān)于森西賽智科技
森西賽智科技服務(wù)產(chǎn)品線涵蓋了基礎(chǔ)醫(yī)學(xué)、藥學(xué)、生命科學(xué)、實驗動物研究領(lǐng)域,技術(shù)平臺包括:基因、分子、蛋白、細胞生物學(xué)和分子影像領(lǐng)域的國際一線高端產(chǎn)品。
網(wǎng)址:https://www.sinsitech.com
關(guān)于AT-Spot系列“酶聯(lián)免疫斑點圖像分析儀”

1.1什么是ELISPOT
酶聯(lián)免疫斑點檢測技術(shù)(Enzyme-linked Immunospot Assay,ELISPOT)是從單細胞水平檢測分泌抗體細胞(ASC)或分泌細胞因子(CK)細胞的一項細胞免疫學(xué)檢測技術(shù),用特異性抗體捕獲培養(yǎng)中的細胞分泌的細胞因子,并以斑點顯色的方式將其表現(xiàn)出來。
ELISPOT的實驗原理和流程如圖2所示,通過捕獲抗體和檢測抗體,和待測細胞因子形成“三明治夾心”,加入酶底物顯色,分泌細胞因子的細胞位置形成“斑點”,用儀器對形成的“斑點”進行成像和計數(shù)分析。所用儀器就是“酶聯(lián)免疫斑點圖像分析儀”。

圖2. ELISPOT的實驗原理和流程。
1.2細胞因子檢測技術(shù)對比
ELISPOT源于ELISA技術(shù),但是超越ELISA技術(shù):靈敏度大幅超越ELISA,能從數(shù)十萬甚至百萬個細胞中檢驗出單個分泌特定蛋白的細胞并能做到準確的分泌細胞計數(shù)(單細胞水平)。捕獲抗體具有高親和力、高特異性及低內(nèi)毒素特性,在以刺激劑激活細胞時,不會影響活化細胞分泌細胞因子。
各種細胞因子檢測技術(shù)對比如圖3所示。由于ELISPOT法具有較高的特異性和敏感性,易操作,成本相對流式細胞分析術(shù)也較低,已被廣泛用于分泌CK細胞檢測或ASC測定中,對探索自身免疫系統(tǒng)疾病發(fā)病機制具有重要意義。

圖3. 細胞因子檢測技術(shù)對比表。
1.3 ELISPOT的優(yōu)勢
單細胞水平檢測。
高通量:96孔板。
直觀可視化:單細胞分泌產(chǎn)物斑點可視化。
樣本量少:檢測同樣數(shù)量的抗原所需的細胞數(shù)遠遠小于其他方法,對于細胞取得難度高的相關(guān)研究非常有幫助。
細胞無損傷,可回收細胞:對于特定細胞(如淋巴細胞)即使在做完ELISPOT檢測后依然不會受損,能繼續(xù)進行下游相關(guān)研究。
1.4 AT-Spot的特點和優(yōu)勢
森西賽智科技的AT-Spot系列“酶聯(lián)免疫斑點圖像分析儀”具有一系列優(yōu)于同類產(chǎn)品的特點和優(yōu)勢,例如:
高質(zhì)量CCD相機、高清晰顯微單筒鏡頭,為您提供穩(wěn)定的最高質(zhì)量影像。
高精度四滑導(dǎo)軌與微步進電機結(jié)合,帶來最好的聚焦及視野重復(fù)性。
封閉環(huán)境配合獨特無影雙光源系統(tǒng),采用LED環(huán)形碗燈,背景均勻一致、中心無亮斑、無色差,去除板孔壁造成幻影、有效識別板孔邊緣。
可區(qū)分真?zhèn)伟唿c,只有暈狀斑點才是真斑點。
具有斑點三維識別功能,可區(qū)分重疊的細胞斑點。
準確區(qū)分孔邊緣的斑點,假點不計入,數(shù)據(jù)更客觀。
可進行特殊板孔斑點處理:如黏連斑點、背景紋路、纖維絲等。
可去除纖維絲,圖像更美觀,不影響斑點計數(shù)。
適用于各種公司的試劑和各種細胞板,通用性強。
軟件按照SOP標準化流程設(shè)計,傻瓜式操作,每步均有操作提示,易于使用。
可進行斑點統(tǒng)計學(xué)分析。
數(shù)據(jù)輸出多樣,可進行多元化96孔板數(shù)據(jù)圖輸出,方便發(fā)表論文。
具有平臺硬復(fù)位、軟復(fù)位功能,客戶能自行恢復(fù)到出廠設(shè)置,輕松解決各種故障問題。
1.5 AT-Spot的圖像示例
圖4. 濾膜區(qū)域剪切,去除孔邊緣的倒影。

圖5. 陽性對照孔、樣本孔和陰性對照孔示例。
圖6. 具有斑點三維識別功能,可區(qū)分重疊的細胞斑點。
圖7. 自動參數(shù)設(shè)定,可設(shè)置:峰值、直徑、色調(diào)、飽和度、對比度、暈狀值、擴散度等參數(shù)。
圖8. 強大的分析軟件,多類型的數(shù)據(jù)輸出。
疫苗開發(fā):疫苗效力評估金標準。
感染性疾病診斷與研究:結(jié)核、乙型肝炎、丙型肝炎、EB病毒、巨細胞病毒、萊姆病等。
癌癥研究:腫瘤反應(yīng)T細胞作用。
免疫治療:免疫治療療程中免疫反應(yīng)監(jiān)控。
移植:移植中排斥反應(yīng)的預(yù)測。
免疫學(xué)基礎(chǔ)研究:根據(jù)檢測的細胞因子的不同,用來區(qū)分被激活的不同的T細胞亞群,如Th1細胞和Th2細胞。
自身免疫疾病診斷病因分析:如I型糖尿病、多發(fā)性硬化、重癥肌無力、系統(tǒng)性紅斑狼瘡等。
過敏機制探討:IL-4誘發(fā)免疫球蛋白亞型轉(zhuǎn)換,其他參與過敏機制之細胞激素研究。
藥物篩選:化合物和藥物免疫學(xué)反應(yīng)的篩選。
1.7 AT-Spot的用戶和文獻

圖9. AT-Spot的部分用戶列表。

圖10. AT-Spot的部分文獻列表。